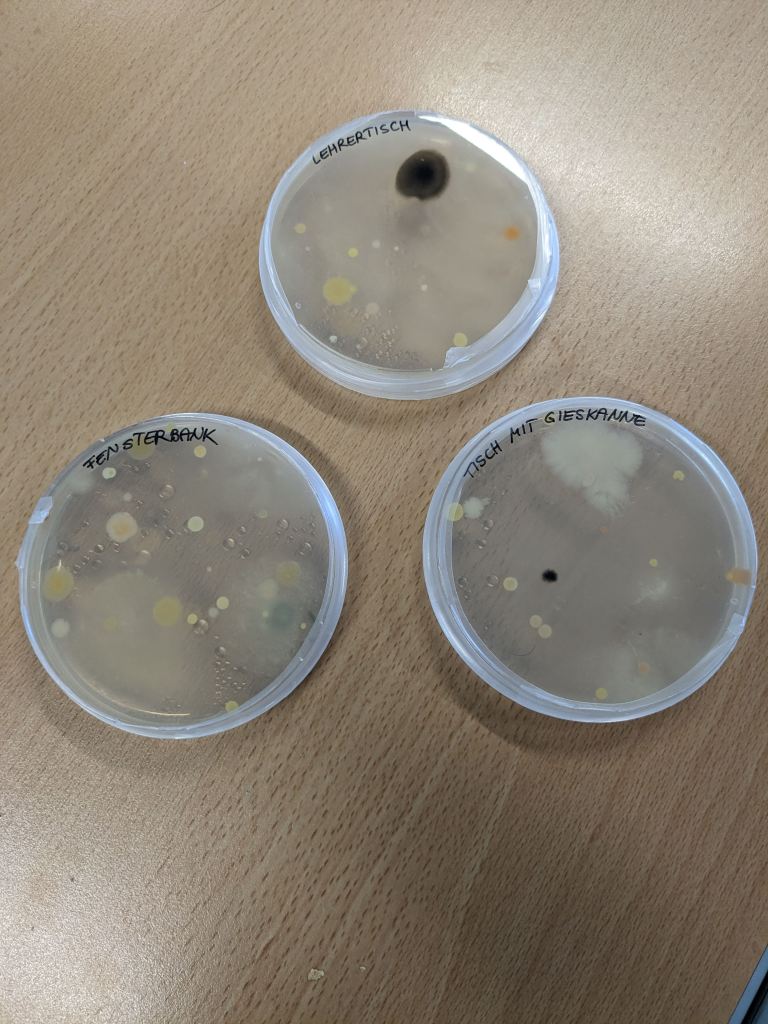

Am 10.5.2023 waren wir (Alexandra, Johanna und Stefan) zum zweiten Mal am BG Vöcklabruck zu Gast. Zuerst gab es einen Vortrag zu unserem Thema, den Bakterien und insbesondere der Artenvielfalt dort. Einige Schüler/innen konnten eine ganze Menge dazu beitragen und wir haben uns über das Interesse sehr gefreut. Wir hoffen, wir konnten vermitteln, dass es bei den Bakterien eine ungeheuere Artenvielfalt gibt, die ganz andere Dimensionen hat, als die der höheren Organismen. Anhand eines ‚Tree of Life‘ konnten die Schüler/innen sehen, dass die Linie der Eukaryoten (zu denen auch wir gehören) im Vergleich zu den Bakterien nur eine kleine Gruppe darstellen, die eine weit weniger starke Auffächerung (so hat es eine Schülerin formuliert und das ist sehr passend) zeigen. So ist das, was wir mit dem bloßen Auge sehen können, nur ein ganz kleiner Teil des Artenreichtums unserer Umgebung. Das ist sogar manchen Biologen nicht bewusst 😉
Dann ging es daran die Agarplatten vom ersten Workshop zu begutachten. Auf den Fotos unten sieht man auch Agarplatten, die wir einige Zeit geöffnet im Klassenzimmer ausgelegt hatten. Darauf sind einige Luftkeime und auch Pilzkolonien gewachsen. Das heißt aber nun nicht, dass es im Klassenzimmer besonders ‚dreckig‘ ist, Bakterien sind eben überall und Pilzsporen ebenso. Interssant war eine Agarplatte, auf der Essig ausgestrichen worden war. Darauf befanden sich viele sehr kleine weiße Kolonien. Wir werden diese Bakterien weiter untersuchen und sind gespannt auf das Ergebnis. Auf einer Agarplatte mit einer Wasserprobe aus einem Brunnen waren Bakterienkolonien, die schon verdächig nach unseren gesuchten Aquirufa-Bakterien aussehen. Die schauen wir uns auch noch genauer an.
Aber das Wichtigste war natürlich mit den gesammelten Wasserproben zu arbeiten. Sie wurden filtriert und dann auf verschiedene Agarplatten gebracht. Das ging dank der Übung im ersten Workshop recht gut. Diesmal waren auch Proben aus sauren Gewässern dabei, aus dem Rauriser Urwald und einem Moor. Jetzt sind wir gespannt, was auf den Platten wächst.
-
Abonnieren
Abonniert
Du hast bereits ein WordPress.com-Konto? Melde dich jetzt an.